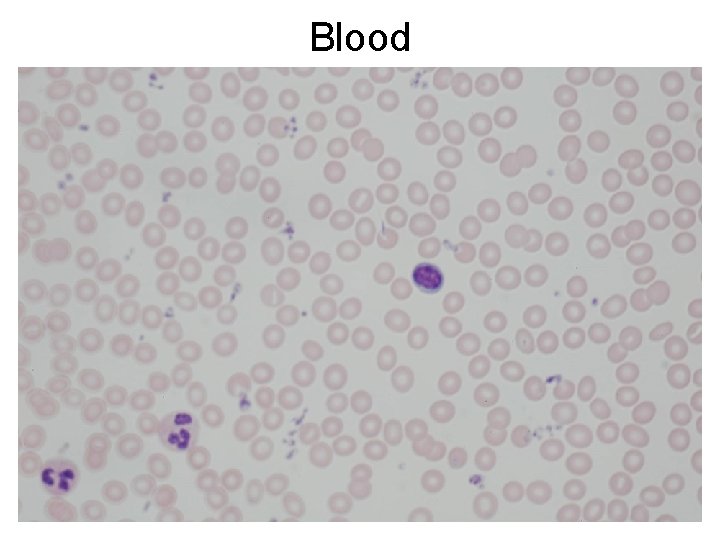
Blood

Lab 5 The Heart and Blood Histology mediastinum

Lab 5: The Heart and Blood Histology

mediastinum

Heart Covering: Pericardium • Pericardium (3 layers) – fibrous pericardium (outer layer) made of dense CT, holds heart in place, prevents overfilling – serous pericardium (2 layers) • parietal layer sticks to fibrous pericardium • visceral layer (= epicardium) is the outermost layer of the heart wall • Between parietal and visceral layers is the pericardial cavity, which contains serous fluid (which reduces friction)

External Features of the Heart The heart has: • A base • An apex • 3 surfaces: – anterior (= sternocostal) – inferior (= diaphragmatic) – posterior (= base)

External Features of the Heart • Sulci (= grooves) – 1 atrioventricular (= coronary sulcus) – 2 interventricular (posterior and anterior interventricular sulci) • L&R auricles (= “flaps”) • Coronary arteries & cardiac veins – Right coronary artery – Left coronary artery – Coronary Sinus (venous) Veins vs Arteries? anterior posterior

The Human Heart has 4 Chambers • L&R atria – Receiving chambers • L&R ventricles – Pumping chambers • The atria are separated by an interatrial septum • The ventricles are separated by an interventricular septum

The Human Heart has 4 Valves • 2 atrioventricular valves: – R atrioventricular (= tricuspid) valve (3 cusps) – L atrioventricular (= mitral or bicuspid) valve (2 cusps) • 2 semilunar valves (each with 3 cusps): – Pulmonary semilunar valve (between R ventricle and pulmonary trunk) – Aortic semilunar valve (between L ventricle and aorta) • Openings to coronary arteries lie in the cusps, called sinuses of Valsalva • Cusps are flaps made of endocardium and reinforced by cores of dense CT

Superior View of Heart Valves

The Fibrous “Skeleton” of the Heart • • Lies within atrioventricular septum Surrounds all 4 valves Made of dense CT Functions: – Anchors valve cusps – Prevents overdilation of valve openings – Serves as an insertion for bundles of cardiac muscle – Blocks direct spread of electrical impulses from atria to ventricles

Special Features of the Heart Wall Pectinate muscles: muscular ridges of right atrium wall Crista Terminalis C-shaped ridge of right atrium Papillary muscles: Cone-shaped, attached to the chordae tendineae Trabeculae carneae: muscular ridges of ventricular walls

Layers of the Heart Wall epicardium myocardium Heart wall endocardium • Epicardium: visceral layer of serous pericardium • Myocardium: consists mainly of cardiac muscle • Endocardium: sheet of endothelium resting on a thin layer of CT; lines heart chambers and makes up heart valves

Blood is pumped through 2 circuits • Pulmonary Circuit: – Blood vessels that carry blood to and from the lungs • Systemic Circuit: – Blood vessels that carry blood to and from the rest of the body

Great Vessels of the Heart Entering L atrium posteriorly: 2 L and 2 R pulmonary VV Superior vena cava R pulmonary A Aorta [A] - ascending - aortic arch - descending L pulmonary A Pulmonary trunk Inferior vena cava

Blood Flow Through the Heart A video: http: //www. heartpoint. com/theheart. html *Which valves are passed at which points?

• The systemic circuit is longer than the pulmonary circuit, therefore the left ventricle must be able to generate greater force and pressure with each pump, than the right ventricle. Note the difference in their wall thicknesses. • Atria are relatively thin walled; they pump blood in the direction of gravity and only have to move blood into the ventricles.

The Heart’s Own Blood Supply • Right coronary artery – Emerges from R side of aorta – Descends in coronary sulcus between R atrium and R ventricle Optional -- Major branches: • Posterior interventricular A (= posterior descending A) • Marginal A • Supplies R atrium, most of R ventricle, and 80% of the time, the inferior portion of the L ventricle as well

The Heart’s Own Blood Supply • Left coronary artery – Arises from L side of Aorta – VERY SHORT Optional -- Major branches: • Circumflex A • Anterior interventricular A (= anterior descending A) • AIA supplies anterior wall of both ventricles • Circumflex supplies L atrium and posterior part of L ventricle

The Heart’s Own Blood Drainage • Cardiac veins – Carry deoxygenated blood from the heart tissues – Almost all venous blood from the heart drains into the coronary sinus, which feeds into the R atrium

• Fetal blood is oxygenated at the placenta, not in the lungs. Most blood that has been oxygenated by the placenta bypasses the lungs via the foramen ovale and the ductus arteriosus • The ductus venosus allows most blood from the placenta to bypass the developing liver Fetal Neonatal

Fetal vessel For now: Ductus arteriosus Foramen ovale Later: Umbilical vein Umbilical arteries Ductus venosus Postnatal derivatives ligamentum arteriosum fossa ovalis ligamentum teres medial umbilical ligaments ligamentum venosum

Adult Remnants of Fetal Heart Ligamentum arteriosum Fossa ovalis - Thin, sheet like

The Cardiac Cycle • Systole= the period of ventricular contraction • Diastole= the period of ventricular relaxation

Chamber-to-Chamber Valves

Chamber-to-Vessel Valves

Heart Sounds • Closure of heart valves causes vibrations in adjacent heart walls and blood; these vibrations constitute the heart sounds • “Lub”: Produced by the closing of AV valves at the start of ventricular systole • “Dub”: Produced by the closing of the semilunar valves at the end of ventricular systole

systole = 1 st heart sound A-V valves close = “lub”

diastole = 2 nd heart sound pulmonic and aortic semilunar valves close = “dub”

The Conduction System of the Heart • Sinoatrial (SA) node • Internodal pathway fibers • Atrioventricular (AV) node • AV bundle (= Bundle of His) • R and L bundle branches • Purkinje fibers

SA node Internodal fibers AV node AV Bundle branches Purkinje fibers

Conduction System of the Heart • Sinoatrial node – Node of muscle cells – Lies in wall of R atrium – Pacemaker of heart, sets basic heart rate – Generates ~70 -80 impulses/minute

Conduction System of the Heart • Atrioventricular node – Impulses travel from SA node via internodal pathway fibers – Located in inferior part of interatrial septum – Impulses that arrive here are delayed for a fraction of a second before passing on to the AV bundle. This allows ventricles to fill before they start to contract

Conduction System of the Heart • Atrioventricular bundle – Enters interventricular septum and divides in to R and L bundle branches – Midway down the interventricular septum, bundle branches split into Purkinje fibers

Conduction System of the Heart • Purkinje Fiber Cells – Approach the apex of the heart and then turn superiorly – This orientation enables contraction of the ventricles to start at the apex and travel superiorly, ejecting the blood up and out into the great arteries

Conduction System of the Heart • Cardiac muscle cells are intrinsically able to generate and conduct impulses • Nodal cells and the cells of the AV bundle are small, but typical cardiac muscle cells • Purkinje fibers are long rows of large diameter, barrel shaped cardiac muscle cells, specialized for conduction more than contraction

Purkinje fiber cells

What controls heart rate? • The intrinsic rate of contraction can be affected by: – Changes in hormone level (epinephrine) – Outside neural controls, specifically those of the Autonomic Nervous System (ANS) • innervates smooth muscle, cardiac muscle, and glands • regulates visceral functions (blood pressure, heart rate, digestion, elimination)

What controls heart rate? There are 2 types of autonomic nervous control: • Parasympathetic: – via Vagus nerve – reduces heart rate and the force of contractions – resting and digesting states • Sympathetic: – increases heart rate and the force of contractions – fight or flight states

Blood - specialized form of connective tissue - components: - blood cells (several types) - plasma (extracellular matrix)

Functions of Blood • Transport nutrients and respiratory gases • Transport waste products to organs and tissues where they can be recycled or released • Transport hormones • Transport immune cells throughout the body • Helps regulate body temperature

Components of Plasma • • • Water (~90%) Nutrients Waste products (CO 2, ammonia, urea) Hormones Oxygen Proteins – including fibrinogen, a clotting factor • Serum = everything in plasma, minus the clotting factors

Relative Amounts of Blood Cells

The Staining of Blood Cells • Blood smears are usually stained with a mix of: – Eosin, an acidic dye that stains pink – Methylene blue, a basic dye that stains blue to purple • Take note of the staining of blood cells in your Wheater’s book and on the prepared slides!

Erythrocytes (RBCs) • Small, biconcave discs • Transport oxygen and CO 2, cytoplasm is full of hemoglobin molecules • Have no nuclei or organelles • Pick up O 2 at lung capillaries and release it at body tissue capillaries • Survive for ~100 -120 days in the circulation. Worn out RBCs are removed by macrophages of the spleen and liver.

Blood cell disorders Sickle cell Spherocyte

Leukocytes • Originate in the bone marrow and released continuously into the blood • Travel in bloodstream but function mainly outside of the bloodstream (in loose CT) • 5 types organized into 2 groups – Granulocytes • Neutrophils • Eosinophils • Basophils – Agranulocytes • Lymphocytes • Monocytes

Granulocytes • cytoplasmic granules (containing enzymes or chemicals) makes cytoplasm look grainy • Non-spherical nuclei with lobes • All are phagocytic; they engulf and consume foreign cells and material • 3 main types

Granulocytes: Neutrophils • Up to 5 lobes in nucleus connected by “threads” of nuclear material • Red nucleus, light purple-pink cytoplasm • Called neutrophils because cytoplasm takes up red (acidic) and blue (basic) stains equally • Specialized for responding to bacterial invasions

Granulocytes: Eosinophils • Usually have bi-lobed nuclei connected by a short “thread” of nuclear material • Large cytoplasmic granules, which stain red with the acidic eosin dye (eosinophil = eosin loving) • Help in ending allergic reactions and in fighting parasitic infections

Granulocytes: Basophils • Rarest leukocyte – might not see these under the microscopes • Usually have bi-lobed, S-shaped nuclei but their granules often makes it hard to see • Has large granules that stain dark purple in basic dyes (basophil = basic loving) • Granules contain histamine and other molecules that mediate inflammation in allergic reactions and parasitic infections

Agranulocytes • Granules in cytoplasm are absent or too small to see – Cytoplasm appears clear blue • 2 types based on structure (not cell lineage): – Lymphocytes – Monocytes

Agranulocytes: Lymphocytes • Dark purple nucleus occupies most of cell volume • Cytoplasm is light blue • Different types of T cells – some directly kill foreign or infected cells; others activate phagocytes to destroy microbes • B cells differentiate into plasma cells – secrete antibodies that bind to specific antigens and mark them for destruction by phagocytic cells Can be confused with basophils!

Agranulocytes: Monocytes • Largest leukocytes • Clear blueish cytoplasm & a large C-shaped purple nucleus • Larger proportion of cytoplasm than lymphocytes • Travel through bloodstream to reach connective tissues, where they transform into macrophages (large phagocytic cells)

Thrombocytes (Platelets) • Disc-shaped, plasma membrane enclosed fragments of cytoplasm • Broken off from larger cells called megakaryocytes • Aids in clotting by plugging tears in vessel walls • Release secretory granules that help recruit other platelets

Blood Cell Formation (Hematopoiesis) • Begins during embryonic development – yolk sac, liver, spleen, bone marrow • Continues throughout life – only in bone marrow after 28 weeks • After birth, all blood cells originate in bone marrow

Bone Marrow and Hematopoiesis • Red bone marrow actively generates blood cells – In adults, found only in vertebrae and girdles, and in the proximal epiphysis of the humerus and femur • Yellow marrow is dormant; only makes blood cells in emergencies – Fat storage – Long bone marrow cavities

The Microscopic Structure of Bone Marrow • Loose reticular CT forms a “labyrinth of caverns” between bone trabeculae where blood cells form • Prevalent cell types include reticular cells (specialized fibroblasts which secrete the fiber network), adipocytes, developing blood cells, macrophages, stem cells

Blood Cell Differentiation One type of blood stem cell which can differentiate into multiple blood stem cell lineages: - RBC lineage - Granular leukocyte lineage -Monocyte lineage - Platelet lineage - Lymphocyte lineage with a different precursor than other blood cells

Bone Marrow megakaryocyte RBCs: some have nuclei
Blood
- Slides: 59